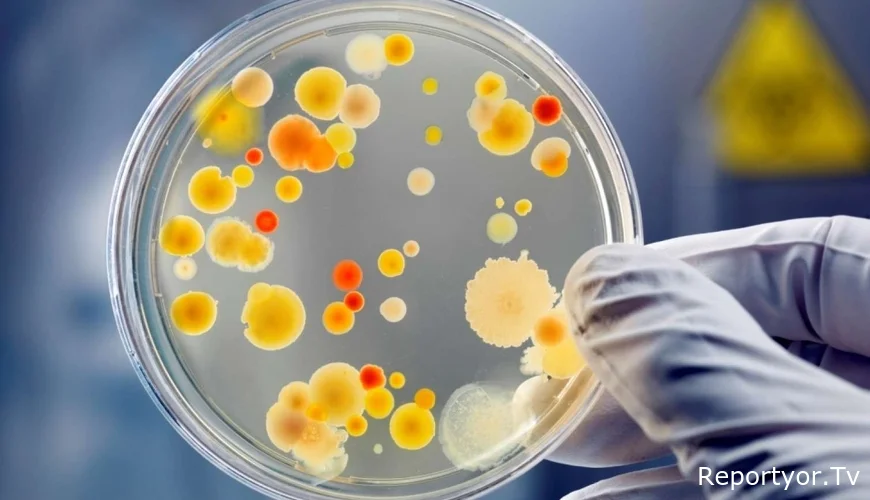
Ölümcül VİRUS sürətlə yayılır – Professordan XƏBƏRDARLIQ

Ümumdünya Səhiyyə Təşkilatının (ÜST) Cenevrədəki nümayəndəsi Tarik Jazareviç bildirib ki, kifayət qədər tədqiqat aparılmadığı üçün Nipah virusunun dünya miqyasında daha geniş yayılma riski mövcuddur.
Musavat.com xəbər verir ki, onun sözlərinə görə, “Hindistan və Banqladeşin bəzi bölgələri, o cümlədən Qərbi Benqal, yarasa populyasiyalarında Nipah virusunun məlum rezervuarını nəzərə alsaq, yoluxma hallarının artması mümkündür”.
Jazareviç həmçinin ictimaiyyətin risk faktorları barədə məlumatlandırılmasının vacibliyini vurğulayıb.
Bir daha xatırladaq ki, Nipah virusuna qarşı nə peyvənd, nə də xüsusi müalicə var. İlk dəfə 1999-cu ildə Malayziyada donuz fermerləri arasında aşkar edilən bu virus, ÜST tərəfindən yüksək riskli patogen hesab olunur. Ölüm hallarının nisbəti 40–75% arasında dəyişir.
Ötən həftə “The Economic Times” qəzetinin məlumatına görə, Hindistanın Qərbi Benqal əyalətinin Kalkutta bölgəsində Nipah virusuna yoluxma baş verib. Beş yoluxma halı təsdiqlənib, onlardan üçü ötən həftə qeydə alınıb. Yoluxanlar arasında həkim, tibb bacısı və digər səhiyyə işçiləri də var. Təmasda olan təxminən 100 nəfər karantinə alınıb.
Epidemiyanın ilk iki halı isə yeni ildən dərhal sonra iki tibb bacısında aşkarlanıb, onlardan biri hazırda komadadır. Yoluxmanın mənbəyi ehtimal ki, laboratoriya müayinəsi aparılmadan əvvəl naməlum xəstəlikdən vəfat etmiş bir şəxsdir.
Bəs bu qorxulu virusa qarşı peyvənd nə qədər vaxta hazır ola bilər? Bu yöndə iş gedirmi? COVİD 19 peyvəndi nə qədər müddətə ərsəyə gəlmişdi. Yeni pandemiya mümkünmü?
Həkim-cərrah, tibb elmləri doktoru Adil Qeybulla mövzu ilə bağlı Musavat.com-a fikrini bölüşüb: “Ümumiyyətlə, virus ilk dəfə məhz bu zonalarda aşkar edilib və Nipah çayının adı ilə adlandırılıb. Bu, zoonotik virusdur – yəni əsasən heyvanlarda mövcud olan, lakin insana da keçə bilən infeksiyadır. Virus ilk olaraq meyvə ilə qidalanan yarasalarda qeydə alınıb. Ehtimal olunur ki, həmin yarasalardan digər növlərə də keçib. 1998-ci ildə ilk dəfə Malayziyada insanlarda yoluxma faktı rəsmi şəkildə qeydə alınıb. Ola bilsin ki, bundan əvvəl də yoluxmalar olub, lakin qeydiyyata alınmış ilk hal məhz həmin dövrə təsadüf edir. Hadisə əsasən donuz fermalarında baş verib. Həmin vaxt təxminən 265–300 nəfərin yoluxduğu, onlardan isə 108 nəfərin həyatını itirdiyi bildirilir.
Virusla bağlı vəziyyət həmin ərəfədə dərhal ciddi nəzarətə götürülüb, lokallaşdırılıb və yayılmasının qarşısı alınıb. Lakin Ümumdünya Səhiyyə Təşkilatı virusun yüksək yoluxduruculuq potensialını və genomunda mutasiyaya meylli olmasını nəzərə alaraq onu təhlükəli viruslar kateqoriyasına daxil edib. Virusun ölümcüllük (letal) göstəricisinin 45–70 faiz arasında olduğu bildirilir ki, bu da onun yüksək risk daşıdığını göstərir. Ümumdünya Səhiyyə Təşkilatının, Xəstəliklərə Nəzarət və Profilaktika Mərkəzlərinin proqnozlarına görə, virus gələcəkdə təhlükəli epidemiyalara səbəb ola bilər”.
Adil Qeybulla qeyd edib ki, ümumilikdə virus orqanizmə ağız boşluğu, burun boşluğu və tənəffüs yolları vasitəsilə daxil olur: “İlk mərhələdə boğaz ağrısı, anginaya bənzər ağrılar, yüksək hərarət, güclü baş və bədən ağrıları müşahidə edilir. Daha sonra ürəkbulanma, qusma, intoksikasiya, halsızlıq, huşun qaranlıqlaşması, ağır hallarda koma və ölüm baş verə bilər. Xəstəliyin ən təhlükəli tərəfi isə onun respirator əlamətlərlə yanaşı, ensefalitə – yəni beyin iltihabına səbəb olmasıdır. Hazırda xəstəlik nəzarət altına götürülüb, Banqladeşdə, Hindistanda və Qərbi Nepal ərazilərində karantin tədbirləri həyata keçirilir. ÜST-nin mütəxəssisləri həmin bölgələrdə fəaliyyət göstərir. Bununla belə, nəzərə almaq lazımdır ki, virus vaxtilə Malayziyada donuz fermalarında aşkar olunmuş və həmin heyvanlara qulluq edən insanlar da yoluxmuşdu. Bu baxımdan təhlükə hələ də qalır. Xüsusilə heyvanların yoluxması və heyvandarlıq təsərrüfatlarında çalışan insanların risk altında olması səbəbindən bütün fermalar ciddi şəkildə yoxlanmalı və daimi nəzarətə götürülməlidir”.
Həkim infeksiyanın Azərbaycana daxil olması tam real sayır: “Çünki qloballaşan dünyada insanların miqrasiyası, turizm, biznes əlaqələri və intensiv gediş-gəliş mövcuddur. Buna görə də maksimum diqqətli olmaq vacibdir. Şübhəli hallarla rastlaşdıqda dərhal izolyasiya tədbirləri görülməli, karantin rejimi tətbiq olunmalı və zəruri profilaktik addımlar atılmalıdır”.






Şərhlər